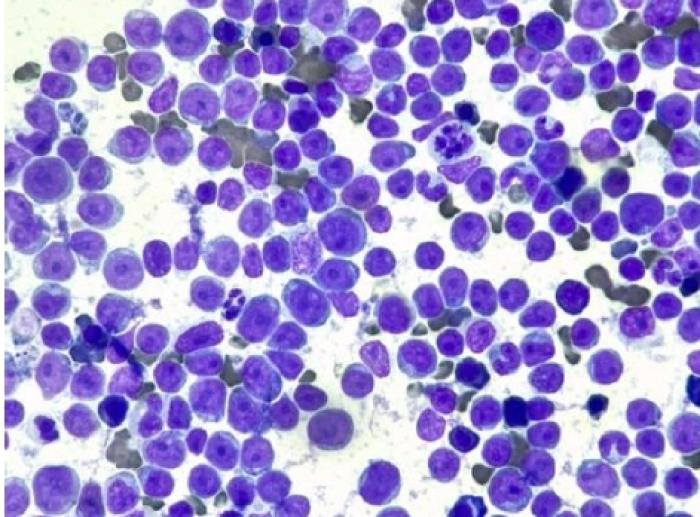

Tratamiento y evolución de un gato con leucemia linfoblástica
Resumen breve
Se reporta el caso de una gata de dos años, esterilizada y positiva al virus de la leucemia felina (FeLV), remitida debido a un cuadro de pancitopenia severa. Los análisis sanguíneos iniciales revelaron anemia, neutropenia y trombocitopenia. El incremento en el recuento de monocitos en la hematología fue atribuido a la presencia de blastos circulantes. Después de administrar una transfusión de concentrado eritrocitario, se procedió a la toma de médula ósea. La citología y la citometría…Índice de contenidos
Resumen
Se reporta el caso de una gata de dos años, esterilizada y positiva al virus de la leucemia felina (FeLV), remitida debido a un cuadro de pancitopenia severa. Los análisis sanguíneos iniciales revelaron anemia, neutropenia y trombocitopenia. El incremento en el recuento de monocitos en la hematología fue atribuido a la presencia de blastos circulantes. Después de administrar una transfusión de concentrado eritrocitario, se procedió a la toma de médula ósea. La citología y la citometría de flujo confirmaron el diagnóstico de una leucemia linfoblástica de células T (CD4+/CD8+).
Se instauró el protocolo quimioterápico CHOP. A pesar del mal pronóstico que se asocia con la leucemia linfoblástica aguda felina (LLA), la paciente experimentó una notable mejoría clínica, junto con una recuperación transitoria de las tres líneas celulares. El tratamiento se mantuvo durante cuatro ciclos completos y fue suspendido tras detectarse un empeoramiento analítico en el quinto ciclo. El tiempo total de supervivencia fue de 234 días, lo cual supera la supervivencia media reportada en la literatura para esta patología en gatos FeLV positivos.
Introducción
La leucemia linfoblástica aguda (LLA) en la especie felina se caracteriza por la expansión clonal de linfocitos inmaduros, habitualmente de origen T. Esta enfermedad se clasifica dentro de las leucemias de origen linfoide y, en un 60-80 % de los casos, se encuentra asociada a la infección por el virus de la leucemia felina (FeLV). Los pacientes afectados suelen manifestar pancitopenia severa y presencia de blastos en la circulación sanguínea.
Debido a que el desarrollo de la vacunación contra FeLV ha propiciado un notable descenso en la incidencia de la LLA, la evidencia científica actual referente al tratamiento es limitada, ya que la mayoría de los reportes provienen de estudios anteriores a la vacunación. Los protocolos quimioterápicos empleados habitualmente, como el CHOP o COP, han ofrecido resultados generalmente pobres, tanto en la remisión como en su duración.
El objetivo de este artículo es describir el diagnóstico, el tratamiento con el protocolo CHOP y la evolución de una gata joven FeLV positiva con LLA, destacando la supervivencia prolongada y la remisión clínica obtenidas.
Caso Clínico
Se remitió al servicio de oncología una gata esterilizada, de 2 años y 3.8 kg de peso, FeLV positiva, a causa de un cuadro de pancitopenia severa, con la intención de realizar una citología de médula ósea. La gata fue recogida de cachorro de una colonia con un cuadro vírico respiratorio y ocular que le ocasionó ceguera.
En la exploración inicial se observó una pérdida de masas musculares, taquipnea y mucosas pálidas. El resto de la exploración no evidenció alteraciones significativas.
Se realizó una hematología cuyos resultados más relevantes se muestran a continuación (Figuras 1-3):
- Eritrocitos: 1.37M/μl
- Hematocrito (Ht): 7.5 %
- Hemoglobina: 2.8g/dl
- Reticulocitos: 4K/μl
- Leucocitos: 7.07K/μl
- Neutrófilos: 0.30K/μl
- Linfocitos: 4.36K/μl
- Monocitos: 2.38K/μl
- Plaquetas: 28K/μl



El frotis de sangre confirmó estos datos. El aumento del recuento de monocitos se correspondió con la presencia de blastos en sangre circulante. Se conoce que los analizadores hematológicos a menudo clasifican estas células grandes como monocitos, representándolas en la parte superior de la gráfica (Figura 4).

Ante estos resultados, y previo a la toma de médula, se llevó a cabo una transfusión sanguínea. El grupo sanguíneo fue tipificado como grupo A y se transfundió una unidad de concentrado eritrocitario de ese mismo grupo sin presentarse incidencias.
El protocolo anestésico utilizado consistió en una premedicación intravenosa de 0.2mg/kg de metadona y 0.2mg/kg de midazolam, logrando un grado de sedación moderado. Previo a la inducción anestésica, se preoxigenó al paciente con mascarilla durante 5 minutos con oxígeno al 100 %. La inducción se realizó por vía intravenosa con alfaxalona 1mg/kg (dosis-efecto). Se procedió a la intubación orotraqueal previa instilación de lidocaína al 2 % en laringe con un tubo endotraqueal de 3.5mm de diámetro. El mantenimiento anestésico se efectuó con isofluorano vehiculado en oxígeno y aire, con una fracción espirada de 1.2-1.3 %. Al finalizar el procedimiento, el paciente se recuperó tranquilamente, sin presentarse complicaciones anestésicas.
La muestra de médula se tomó del húmero derecho con una aguja de Jamshidi y una jeringa de 10cc. El material extraído se depositó en tubo con EDTA (para la citometría) y en portaobjetos (para la citología). Todo el procedimiento transcurrió sin complicaciones.
La citología mostró que más del 50 % de las células nucleadas correspondían a formas blásticas, con núcleos prominentes, de un tamaño de 2-3 glóbulos rojos, con morfología redondeada, marcada anisocariosis y grandes nucleolos. Los citoplasmas eran escasos y basófilos. Se observó una notable ausencia de las líneas mieloide y eritroide, y no se identificaron megacariocitos. El diagnóstico fue compatible con una leucemia aguda, probablemente linfoblástica (Figuras 5-6).

La citometría de flujo arrojó los siguientes resultados (Figura 7):
- Viabilidad: 99.9 % células vivas
- Porcentaje de células CD45+/CD21+ = 0.3 %
- Porcentaje de células CD45+/CD5+ = 81.9 %
- Proporción de células CD4+/CD4+ = 0.6 %
- Proporción de células CD4+/CD8+ = 4.5 %
- Proporción de células CD45+/CD5+/CD4+/CD8+ = 95 %
- Relación tamaño T/B: 2.03

Interpretación: compatible con leucemia linfoblástica de células T (CD4+/CD8+)
Comentario: la población celular mayoritaria en la médula ósea de la paciente fueron células blásticas (con un tamaño promedio 2.3 veces mayor que un linfocito normal), las cuales expresaron los marcadores característicos de linfocitos T (CD45+/CD21−/CD5+) y, en su mayoría, presentaron doble expresión CD4+/CD8+, lo cual puede ser interpretado como una aberración fenotípica.
Se decidió iniciar el protocolo CHOP con hemograma previo en cada sesión (Figura 8).

Evolución del tratamiento
La primera sesión se llevó a cabo 4 días después de la visita inicial. El hematocrito era de 14.9 % gracias a la transfusión, manteniéndose la neutropenia y trombocitopenia. Se aplicó un bolo de vincristina (0.6mg/m2) y se comenzó con prednisona (2mg/kg/día) (ver Figuras 1-3).
A los 7 días, la gata mostraba buena calidad de vida y sin efectos secundarios. El hemograma reflejó un hematocrito de 11.5 % (ver Figuras 1-3). No se transfundió al no presentar sintomatología y por el inicio del aumento de reticulocitos (de 3 a 8.1K/μl). Se mantuvieron la neutropenia y trombocitopenia. Se administró la dosis de ciclofosfamida por vía oral y se redujo la prednisona a 1mg/kg/día.
A los 7 días (tercera sesión/segunda vincristina), la calidad de vida era buena. El hemograma mostró un hematocrito más bajo (9.3 %), pero con un claro aumento de reticulocitos (68.8K/μl y 4.7 %) (ver Figuras 1-3). Se aplicó vincristina y se disminuyó la prednisona a 0.5mg/kg/día.
La semana siguiente se notificó una mejoría evidente en la actividad de la paciente. El hemograma de esa sesión mostró por primera vez un aumento de las tres líneas celulares, con los neutrófilos en rango normal (2.73K/μl; Rango 2.30−10.29K/μl) (ver Figuras 1-3). Se aplicó la dosis de doxorrubicina, completando el primer ciclo. La prednisolona se mantuvo a 0.5mg/kg/48 h.
Quince días después, se inició el segundo ciclo con la paciente asintomática y analíticas normales (ver Figuras 1-3). En la aplicación de doxorrubicina (sesión 8), se produjo una extravasación que requirió aspiración y aplicación de frío local. No hubo lesiones, pero el tercer ciclo se retrasó una semana (Figura 9).

Durante el tercer ciclo, la paciente continuó estable, ganando peso, pero tras la segunda vincristina (sesión 11) se desarrolló neutropenia (0.66K/μl) (ver Figuras 1-3). Al no haber fiebre, la administración de doxorrubicina se postergó una semana. A la semana siguiente, la neutropenia se había recuperado (2.54K/μl), permitiendo su administración.
En la revisión de la primera sesión del cuarto ciclo (sesión 13) reapareció la neutropenia (0.89K/μl), por lo que el tratamiento se retrasó una semana más (ver Figuras 1-3).
A la semana, se detectó una alteración analítica más seria, con neutropenia, monocitosis y trombocitopenia. El frotis confirmó la presencia de blastos circulantes (monocitosis aparente). Ante este claro empeoramiento, se decidió continuar con el tratamiento a pesar de la neutropenia, completando el cuarto ciclo, el cual fue bien tolerado, aunque sin mejoría analítica (ver Figuras 1-3).
Tras la primera vincristina del quinto ciclo, el hemograma continuó deteriorándose, por lo que se decidió suspender el tratamiento, manteniendo únicamente la prednisolona oral (ver Figuras 1-3).
La última visita ocurrió dos semanas más tarde, con el hemograma en franco deterioro. Un mes después, los tutores informaron del fallecimiento de la paciente por eutanasia humanitaria, debido a la caída de la calidad de vida. La supervivencia total fue de 234 días.
Discusión y conclusiones
En la especie felina, las leucemias se clasifican en mieloides y linfoides, las cuales pueden ser agudas (de precursores o blastos) o crónicas (de células maduras). La leucemia linfoblástica aguda (LLA) es usualmente una expansión clonal de linfocitos T. En concordancia con el caso presentado, la LLA en gatos FeLV positivos se manifiesta típicamente con pancitopenia severa y blastos en la circulación sanguínea.
La evidencia científica actual es limitada, ya que la mayoría de los reportes fueron publicados antes de la era de la vacunación contra FeLV, lo que resulta en datos de pronóstico y supervivencia escasos y generalmente desfavorables.
A pesar de que los protocolos quimioterápicos tipo COP o CHOP suelen ofrecer resultados limitados tanto en la remisión como en su duración, la paciente logró una supervivencia de 234 días con una buena calidad de vida. Además, se alcanzó una remisión completa durante un periodo. Estos datos son superiores a los encontrados en la literatura para la LLA felina. La buena respuesta inicial a la quimioterapia y la gestión de los efectos secundarios (como la neutropenia y la extravasación) permitieron prolongar la calidad de vida hasta que el empeoramiento analítico y el descenso de la calidad de vida obligaron a la suspensión del tratamiento.
Bibliografía
- Cotter SM: Treatment of lymphoma and leukemia with cyclophosphamide,vincristine and prednisone: I. Treatment of dogs, J Am Anim Hosp Assoc 19:159–165, 1983
- Gorman NT, Evans RJ: Myeloproliferative disease in the dog and cat: clinical presentations, diagnosis and treatment, Vet Rec 121:490–496, 1987
- Grindem C: Morphological and clinical an pathological characteristics of spontaneous leukemia in 10 cats, J Am Anim Hosp Assoc 21:227, 1985.
- Tomiyasu H, Doi A, Chambers JK, Goto-Koshino Y, Ohmi A, Ohno K, Tsujimoto H. Clinical and clinicopathological characteristics of acute lymphoblastic leukaemia in six cats. J Small Anim Pract. 2018 Dec;59(12):742-746. doi: 10.1111/jsap.12917. Epub 2018 Aug 31. PMID: 30168590
- Vail DM, Pinkerton M, Young KM. Hematopoietic tumors. En Withrow SJ, Vail DM, Tham DH. Withrow & MacEwen’s Small Animal Clinical Oncology. 6th edition. 2020. ISBN: 978-0-323-59496-7. P. 688-772